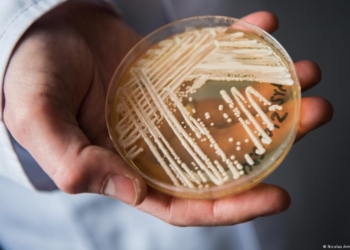
Sesap confirma novo caso de “superfungo” em hospital de Natal

Cantor Junior Vianna é diagnosticado com leptospirose
14 de dezembro de 2023
Movida por um sonho: Mossoroense é aprovada no Instituto Tecnológico de Aeronáutica
3 de janeiro de 2024
Caern suspenderá abastecimento em quatro bairros para manutenção no Poço 14
23 de outubro de 2024
Posto de combustível vende gasolina quase R$ 1,00 mais barata e atrai grande fila
17 de agosto de 2024
Potiguar mandará partida da semifinal contra o América na Arena das Dunas
5 de março de 2026
Prefeitura inicia pavimentação de 18 ruas no Bairro Bela Vista, em Mossoró
5 de março de 2026
Sesap confirma novo caso de “superfungo” em hospital de Natal
5 de março de 2026